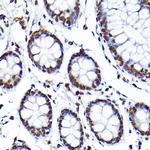
SAFB Antibody in Immunohistochemistry (Paraffin) (IHC (P))

Search
Invitrogen
SAFB Polyclonal Antibody
{{$productOrderCtrl.translations['antibody.pdp.commerceCard.promotion.promotions']}}
{{$productOrderCtrl.translations['antibody.pdp.commerceCard.promotion.viewpromo']}}
{{$productOrderCtrl.translations['antibody.pdp.commerceCard.promotion.promocode']}}: {{promo.promoCode}} {{promo.promoTitle}} {{promo.promoDescription}}. {{$productOrderCtrl.translations['antibody.pdp.commerceCard.promotion.learnmore']}}

Please note: We are reviewing Western blot images included in the antibody testing data in our catalog, including those provided by third parties. Unless expressly labeled or annotated as “raw-unedited”, Western blot images included in the antibody testing data in our catalog may have been edited, optimized or otherwise adjusted for presentation.
产品信息
PA5-117111
种属反应
宿主/亚型
分类
类型
抗原
偶联物
形式
浓度
规格
纯化类型
保存液
内含物
保存条件
运输条件
RRID
产品详细信息
Positive Samples: U-87MG, DU145, NIH/3T3, Mouse brain, Mouse lung, Rat brain
Immunogen sequence: MAETLSGLGD SGAAGAAALS SASSETGTRR LSDLRVIDLR AELRKRNVDS SGNKSVLMER LKKAIEDEGG NPDEIEITSE GNKKTSKRSS KGRKPEEEGV EDNGLEENSG DGQEDVETSL ENLQDIDIMD ISVLDEAEID NGSVADCVED DDADNLQESL SDSRELVEGE MKELPEQLQE HAIEDKETIN NLDTSSSDFT
靶标信息
This gene encodes a DNA-binding protein which has high specificity for scaffold or matrix attachment region DNA elements (S/MAR DNA). This protein is thought to be involved in attaching the base of chromatin loops to the nuclear matrix but there is conflicting evidence as to whether this protein is a component of chromatin or a nuclear matrix protein. Scaffold attachment factors are a specific subset of nuclear matrix proteins (NMP) that specifically bind to S/MAR. The encoded protein is thought to serve as a molecular base to assemble a 'transcriptosome complex' in the vicinity of actively transcribed genes. It is involved in the regulation of heat shock protein 27 transcription, can act as an estrogen receptor co-repressor and is a candidate for breast tumorigenesis. This gene is arranged head-to-head with a similar gene whose product has the same functions. Multiple transcript variants encoding different isoforms have been found for this gene.
仅用于科研。不用于诊断过程。未经明确授权不得转售。
篇参考文献 (0)
生物信息学
蛋白别名: DKFZp779C1727; HSP27 ERE-TATA-binding protein; HSP27 estrogen response element-TATA box-binding protein; SAF-B; SAF-B1; Scaffold attachment factor B1
基因别名: 3110021E02Rik; 5330423C17Rik; AU018122; D18386; E130307D12; HAP; HET; SAF-B1; SAFB; SAFB1
UniProt ID: (Mouse) D3YXK2
Entrez Gene ID: (Mouse) 224903, (Rat) 64196




